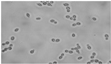

Use of Nonconventional Yeasts for Modulating Wine Acidity
Abstract
:1. Acids Present in Grapes and Wines and Their Perceived Taste
2. Wine Biological Acidity Modulation by Bacteria via Malolactic Fermentation
3. Wines Biological Acidity Modulation by Nonconventional Yeasts
3.1. Lachancea thermotolerans: Wine Acidification/Deacetification
3.2. Schizosaccharomyces pombe: Biological Acidity Modulation via Maloalcoholic Fermentation
3.3. Candida stellata: Biological Acidity Enrichment
3.4. Torulaspora delbrueckii: Volatile Acidity Modulation in Very Sweet Musts
3.5. Zygosaccharomyces Florentinus/Zygotorulaspora Florentina: Volatile Acidity Modulation
3.6. Pichia kudriavzevii/Issatchenkia orientalis: Malic Acid Consumption
3.7. Starmerella bacillaris/Candida zemplinina: Wine Biological Acidification and Deacidification
4. Final Remarks
Acknowledgments
Conflicts of Interest
References
- Liu, H.F.; Wu, B.H.; Fan, P.G.; Xu, H.Y.; Li, S.H. Inheritance of sugars and acids in berries of grape (Vitis vinifera L.). Euphytica 2007, 153, 99–107. [Google Scholar] [CrossRef]
- Cosme, F.; Gonçalves, B.; Inês, A.; Jordão, A.M.; Vilela, A. Grape and wine metabolites: Biotechnological approaches to improve wine quality. In Grape and Wine Biotechnology; Morata, A., Loira, I., Eds.; InTechOpen: London, UK, 2016; pp. 187–214. [Google Scholar]
- Amerine, M.A. The Maturation of Wine Grapes. Wines Vines 1956, 37, 53–55. [Google Scholar]
- Stafford, H. Distribution of Tartaric Acid in the Leaves of Certain Angiosperms. Am. J. Bot. 1959, 46, 347–352. [Google Scholar] [CrossRef]
- Kliewer, W. Sugars and Organic Acids of Vitis vinifera. Plant Physiol. 1966, 41, 923–931. [Google Scholar] [CrossRef] [PubMed]
- Lamikanra, O.; Inyang, I.; Leong, S. Distribution and effect of grape maturity on organic acid content of red Muscadine grapes. J. Agric. Food Chem. 1995, 43, 3026–3028. [Google Scholar] [CrossRef]
- Ford, C.M. The Biochemistry of Organic Acids in the Grape. In The Biochemistry of the Grape Berry; e-Book, Gerós, H., Chaves, M., Delrot, S., Eds.; Bentham Science Publishers: Sharjah, UAE, 2012; pp. 67–88. ISBN 978-1-60805-360-5. [Google Scholar]
- Boulton, R.B.; Singleton, V.L.; Bisson, L.F.; Kunkee, R.E. Principles and Practices of Winemaking; Chapman and Hall: New York, NY, USA, 1996; pp. 102–181. [Google Scholar]
- Sharma, R.K. Citric Acid. In Natural Food Antimicrobial Systems; Naidu, A.S., Ed.; CRC Press LLC: New York, NY, USA, 2000. [Google Scholar]
- Citric Acid Cycle. Available online: https://commons.wikimedia.org/wiki/File:Citric_acid_cycle_with_aconitate_2.svg#/media/File:Citric_acid_cycle_with_aconitate_2.svg (accessed on 30 January 2019).
- Ribéreau-Gayon, P.; Glories, Y.; Maujean, A.; Dubourdieu, D. Alcohols, and other volatile compounds. The chemistry of wine stabilization and treatments. In Handbook of Enology, 2nd ed.; John Wiley & Sons Ltd.: Chichester, UK, 2006; Volume 2, pp. 51–64. [Google Scholar]
- Office Internationale de la Vigne et du Vin. International Code of Oenological Practices; OIV: Paris, France, 2010. [Google Scholar]
- Vilela-Moura, A.; Schuller, D.; Mendes-Faia, A.; Silva, R.F.; Chaves, S.R.; Sousa, M.J.; Côrte-Real, M. The impact of acetate metabolism on yeast fermentative performance and wine quality: Reduction of volatile acidity of grape musts and wines—Minireview. Appl. Microbiol. Biotechnol. 2011, 89, 271–280. [Google Scholar] [CrossRef] [PubMed]
- Coulter, A.D.; Godden, P.W.; Pretorius, I.S. Succinic acid-how is it formed, what is its effect on titratable acidity, and what factors influence its concentration in wine? Wine Ind. J. 2004, 19, 16–24. [Google Scholar]
- Hopfer, H.; Heymann, H. Judging wine quality: Do we need experts, consumers or trained panelists? Food Qual. Prefer. 2014, 32, 221–233. [Google Scholar] [CrossRef]
- Pretorius, I.S. Tailoring wine yeast for the new millennium: Novel approaches to the ancient art of winemaking. Yeast 2000, 16, 675–729. [Google Scholar] [CrossRef]
- Dicks, L.M.T.; Dellaglio, F.; Collins, M.D. Proposal to reclassify Leuconostoc oenos as Oenococcus oeni [corrig.] gen. nov., comb. nov. Int. J. Syst. Bacteriol. 1995, 45, 395–397. [Google Scholar] [CrossRef] [PubMed]
- Henick-Kling, T. Malolactic fermentation. In Wine Microbiology and Biotechnology; Fleet, G.H., Ed.; Harwood Academic Publishers: Reading, UK, 1993; pp. 289–327. [Google Scholar]
- Volschenk, H.; Van Vuuren, H.J.J.; Viljoen-Bloom, M. Malic acid in wine: Origin, function and metabolism during vinification. S. Afr. J. Enol. Vitic. 2006, 27, 123–136. [Google Scholar] [CrossRef]
- Lasik-Kurdyś, M.; Majcher, M.; Nowak, J. Effects of Different Techniques of Malolactic Fermentation Induction on Diacetyl Metabolism and Biosynthesis of Selected Aromatic Esters in Cool-Climate Grape Wines. Molecules 2018, 23, 2549. [Google Scholar] [CrossRef] [PubMed]
- Bartowsky, E.; Borneman, A. Genomic variations of Oenococcus oeni strains and the potential to impact on malolactic fermentation and aroma compounds in wine. Appl. Microbiol. Biotechnol. 2011, 92, 441–447. [Google Scholar] [CrossRef] [PubMed]
- Lerm, E.; Engelbrecht, L.; du Toit, M. Malolactic fermentation: The ABC’s of MLF. S. Afr. J. Enol. Vitic. 2010, 31, 186–212. [Google Scholar] [CrossRef]
- Alexandre, H.; Costello, P.J.; Remize, F.; Guzzo, J.; Guilloux-Benatier, M. Saccharomyces cerevisiae-Oenococcus oeni interactions in wine: Current knowledge and perspectives. Int. J. Food Microbiol. 2004, 93, 141–154. [Google Scholar] [CrossRef]
- Nehme, N.; Mathieu, F.; Taillandier, P. Impact of the co-culture of Saccharomyces cerevisiae-Oenococcus oeni on malolactic fermentation and partial characterization of a yeast-derived inhibitory peptidic fraction. Food Microbiol. 2010, 27, 150–157. [Google Scholar] [CrossRef] [PubMed]
- Berbegal, C.; Peña, N.; Russo, P.; Grieco, F.; Pardo, I.; Ferrer, S.; Spano, G.; Capozzi, V. Technological properties of Lactobacillus plantarum strains isolated from grape must fermentation. Food Microbiol. 2016, 57, 187–194. [Google Scholar] [CrossRef] [PubMed]
- Lucio, O.; Pardo, I.; Krieger-Weber, S.; Heras, J.M.; Ferrer, S. Selection of Lactobacillus strains to induce biological acidification in low acidity wines. LWT Food Sci. Technol. 2016, 73, 334–341. [Google Scholar] [CrossRef]
- Matthews, A.; Grimaldi, A.; Walker, M.; Bartowsky, E.; Grbin, P.; Jiranek, V. Lactic acid bacteria as a potential source of enzymes for use in vinification. Appl. Environ. Microbiol. 2004, 70, 5715–5731. [Google Scholar] [CrossRef]
- Grimaldi, A.; Bartowsky, E.; Jiranek, V. Screening of Lactobacillus spp. and Pediococcus spp. for glycosidase activities that are important in enology. J. Appl. Microbiol. 2005, 99, 1061–1069. [Google Scholar] [CrossRef]
- Brizuela, N.; Tymczyszyn, E.E.; Semorile, L.C.; La Hens, D.V.; Delfederico, L.; Hollmann, A.; Bravo-Ferrada, B. Lactobacillus plantarum as a malolactic starter culture in winemaking: A new (old) player? Electron. J. Biotechnol. 2019, 38, 10–18. [Google Scholar] [CrossRef]
- Du Toit, M.; Engelbrecht, L.; Lerm, E.; Krieger-Weber, S. Lactobacillus: The next generation of malolactic fermentation starter cultures—An overview. Food Bioprocess Techmol. 2011, 4, 876–906. [Google Scholar] [CrossRef]
- Lerm, E.; Engelbrecht, L.; Toit, M.D. Selection and Characterisation of Oenococcus oeni and Lactobacillus plantarum South African Wine Isolates for Use as Malolactic Fermentation Starter Cultures. S. Afr. J. Enol. Vitic. 2011, 32, 280–295. [Google Scholar] [CrossRef]
- Olguín, N.; Bordons, A.; Reguant, C. Multigenic expression analysis as an approach to understanding the behavior of Oenococcus oeni in wine-like conditions. Int. J. Food Microbiol. 2010, 144, 88–95. [Google Scholar] [CrossRef]
- Miller, B.J.; Franz, C.M.; Cho, G.S.; du Toit, M. Expression of the malolactic enzyme gene (mle) from Lactobacillus plantarum under winemaking conditions. Curr. Microbiol. 2011, 62, 1682–1688. [Google Scholar] [CrossRef]
- Iorizzo, M.; Testa, B.; Lombardi, S.J.; García-Ruiz, A.; Muñoz-González, C.; Bartolomé, B.; Moreno-Arribas, M.V. Selection and technological potential of Lactobacillus plantarum bacteria suitable for wine malolactic fermentation and grape aroma release. LWT Food Sci. Technol. 2016, 73, 557–566. [Google Scholar] [CrossRef]
- Bravo-Ferrada, B.M.; Hollmann, A.; Delfederico, L.; La Hens, D.V.; Caballero, A.; Semorile, L. Patagonian red wines: Selection of Lactobacillus plantarum isolates as potential starter cultures for malolactic fermentation. World J. Microbiol. Biotechnol. 2013, 29, 1537–1549. [Google Scholar] [CrossRef]
- Berbegal, C.; Spano, G.; Tristezza, M.; Grieco, F.; Capozzi, V. Microbial Resources and Innovation in the Wine Production Sector. S. Afr. J. Enol. Vitic. 2017, 38, 156–166. [Google Scholar] [CrossRef]
- Benito, A.; Calderón, F.; Palomero, F.; Benito, S. Combined use of selected Schizosaccharomyces pombe and Lachancea thermotolerans yeast strains as an alternative to the traditional malolactic fermentation in red wine production. Molecules 2015, 20, 9510–9523. [Google Scholar] [CrossRef]
- Morata, A.; Suárez-Lepe, J.A. New biotechnologies for wine fermentation and ageing. In Advances in Food Biotechnology, 1st ed.; Ravishankar Rai, V., Ed.; John Wiley & Sons, Ltd.: West Sussex, UK, 2016; pp. 287–301. [Google Scholar]
- Vilela, A. Targeting Demalication and Deacetification Methods: The Role of Carboxylic Acids Transporters. Biochem. Physiol. 2017, 6, 224. [Google Scholar] [CrossRef]
- Vilela, A. Lachancea thermotolerans, the Non-Saccharomyces Yeast that Reduces the Volatile Acidity of Wines. Fermentation 2018, 4, 56. [Google Scholar] [CrossRef]
- Suárez-Lepe, J.A.; Morata, A. New trends in yeast selection for winemaking. Trends Food Sci. Technol. 2012, 23, 39–50. [Google Scholar] [CrossRef]
- Ferraro, L.; Fatichenti, F.; Ciani, M. Pilot scale vinification process using immobilized Candida stellata cells and Saccharomyces cerevisiae. Process. Biochem. 2000, 35, 1125–1129. [Google Scholar] [CrossRef]
- Bely, M.; Stoeckle, P.; Masneuf Pomarède, I.; Dubourdieu, D. Impact of mixed Torulaspora delbrueckii Saccharomyces cerevisiae culture on high sugar fermentation. Int. J. Food Microbiol. 2008, 122, 312–320. [Google Scholar] [CrossRef] [PubMed]
- Velázquez, R.; Zamora, E.; Álvarez, M.L.; Hernández, L.M.; Ramírez, M. Effects of new Torulaspora delbrueckii killer yeasts on the must fermentation kinetics and aroma compounds of white table wine. Front. Microbiol. 2015, 6, 1222. [Google Scholar] [CrossRef] [PubMed]
- Pacheco, A.; Santos, J.; Chaves, S.; Almeida, J.; Leão, C.; Sousa, M.J. The Emerging Role of the Yeast Torulaspora delbrueckii in Bread and Wine Production: Using Genetic Manipulation to Study Molecular Basis of Physiological Responses. In Structure and Function of Food Engineering; Eissa, A.A., Ed.; IntechOpen: London, UK, 2012; Chapter 13; pp. 339–370. [Google Scholar]
- Lencioni, L.; Romani, C.; Gobbi, M.; Comitini, F.; Ciani, M.; Domizio, P. Controlled mixed fermentation at winery scale using Zygotorulaspora florentina and Saccharomyces cerevisiae. Int. J. Food Microbiol. 2016, 234, 36–44. [Google Scholar] [CrossRef] [PubMed]
- Lencioni, L.; Taccari, M.; Ciani, M.; Domizio, P. Zygotorulaspora florentina and Starmerella bacillaris in multistarter fermentation with Saccharomyces cerevisiae to reduce volatile acidity of high sugar musts. Aust. J. Grape Wine Res. 2018, 24, 368–372. [Google Scholar] [CrossRef]
- Domizio, P.; Romani, C.; Lencioni, L.; Comitini, F.; Gobbi, M.; Mannazzu, I.; Ciani, M. Outlining a future for non-Saccharomyces yeasts: Selection of putative spoilage wine strains to be used in association with Saccharomyces cerevisiae for grape juice fermentation. Int. J. Food Microbiol. 2011, 147, 170–180. [Google Scholar] [CrossRef]
- Pina, C.; Gonçalves, P.; Prista, C.; Loureiro-Dias, M.C. Ffz1, a New Transporter Specific for Fructose from Zygosaccharomyces bailii. Microbiology 2004, 150, 2429–2433. [Google Scholar] [CrossRef]
- Vilela-Moura, A.; Schuller, D.; Mendes-Faia, A.; Côrte-Real, M. Reduction of volatile acidity of wines by selected yeast strains. Appl. Microbiol. Biotechnol. 2008, 80, 881–890. [Google Scholar] [CrossRef]
- Mónaco, S.; Barda, N.; Rubio, N.; Caballero, A. Selection and characterization of a Patagonian Pichia kudriavzevii for wine deacidification. J. Appl. Microbiol. 2014, 117, 451–464. [Google Scholar] [CrossRef] [PubMed]
- Hello, My Name is Pichia kudriavzevii; Eureka Brewing. Available online: https://eurekabrewing.wordpress.com/2014/02/16/hello-my-name-is-pichia-kudriavzevii (accessed on 16 February 2019).
- Englezos, V.; Rantsiou, K.; Cravero, F.; Torchio, F.; Ortiz-Julien, A.; Gerbi, V.; Rolle, L.; Cocolin, L. Starmerella bacillaris and Saccharomyces cerevisiae mixed fermentations to reduce ethanol content in wine. Appl. Microbiol. Biotechnol. 2016, 100, 5515–5526. [Google Scholar] [CrossRef]
- Masneuf-Pomarede, I.; Juquin, E.; Miot-Sertier, C.; Renault, P.; Laizet, Y.; Salin, F.; Alexandre, H.; Capozzi, V.; Cocolin, L.; Colonna-Ceccaldi, B.; et al. The yeast Starmerella bacillaris (synonym Candida zemplinina) shows high genetic diversity in winemaking environments. FEMS Yeast Res. 2015, 5, fov045. [Google Scholar] [CrossRef] [PubMed]
- Englezos, V.; Giacosa, S.; Rantsiou, K.; Rolle, L.; Cocolin, L. Starmerella bacillaris in winemaking: Opportunities and risks. Curr. Opin. Food Sci. 2017, 17, 30–35. [Google Scholar] [CrossRef]
- Sadoudi, M.; Tourdot-Maréchal, R.; Rousseaux, S.; Steyer, D.; Gallardo-Chacón, J.-J.; Ballester, J.; Vichi, S.; Guérin-Schneider, R.; Caixach, J.; Alexandre, H. Yeast–yeast interactions revealed by aromatic profile analysis of Sauvignon Blanc wine fermented by single or co-culture of non-Saccharomyces and Saccharomyces yeasts. Food Microbiol. 2012, 2, 243–253. [Google Scholar] [CrossRef] [PubMed]
- Englezos, V.; Rantsiou, K.; Cravero, F.; Torchio, F.; Pollon, M.; Fracassetti, D.; Ortiz-Julien, S.; Gerbi, V.; Rolle, L.; Cocolin, L. Volatile profile of white wines fermented with sequential inoculation of Starmerella bacillaris and Saccharomyces cerevisiae. Food Chem. 2018, 257, 350–360. [Google Scholar] [CrossRef]
- Kapsopoulou, K.; Kapaklis, A.; Spyropoulos, H. Growth and fermentation characteristics of a strain of the wine yeast Kluyveromyces thermotolerans isolated in Greece. World J. Microbiol. Biotechnol. 2005, 21, 1599–1602. [Google Scholar] [CrossRef]
- Gobbi, M.; Comitini, F.; Domizio, P.; Romani, C.; Lencioni, L.; Mannazzu, I.; Ciani, M. Lachancea thermotolerans and Saccharomyces cerevisiae in simultaneous and sequential co-fermentation: A strategy to enhance acidity and improve the overall quality of wine. Food Microbiol. 2013, 33, 271–281. [Google Scholar] [CrossRef]
- Balikci, E.K.; Tanguler, H.; Jolly, N.P.; Erten, H. Influence of Lachancea thermotolerans on cv. Emir wine fermentation. Yeast 2016, 33, 313–321. [Google Scholar] [CrossRef]
- Benito, Á.; Calderón, F.; Palomero, F.; Benito, S. Quality and composition of Airén wines fermented by sequential inoculation of Lachancea thermotolerans and Saccharomyces cerevisiae. Food Technol. Biotechnol. 2016, 54, 135–144. [Google Scholar] [CrossRef]
- Benito, Á.; Jeffares, D.; Palomero, F.; Calderón, F.; Bai, F.Y.; Bähler, J.; Benito, S. Selected Schizosaccharomyces pombe Strains Have Characteristics That Are Beneficial for Winemaking. PLoS ONE 2016, 11, e0151102. [Google Scholar] [CrossRef] [PubMed]
- Salmon, J.M. L-Malic acid permeation in resting cells of anaerobically grown Saccharomyces cerevisiae. Biochim. Biophys. Acta 1987, 901, 30–34. [Google Scholar] [CrossRef]
- Volschenk, H.; Vuuren, H.J.; Viljoen–Bloom, M. Malo-ethanolic fermentation in Saccharomyces and Schizosaccharomyces. Curr. Genet. 2003, 43, 379–391. [Google Scholar] [CrossRef] [PubMed]
- Loira, I.; Morata, A.; Comuzzo, P.; Callejo, M.J.; González, C.; Calderón, F.; Suárez-Lepe, J.A. Use of Schizosaccharomyces pombe and Torulaspora delbrueckii strains in mixed and sequential fermentations to improve red wine sensory quality. Food Res. Int. 2015, 76, 325–333. [Google Scholar] [CrossRef]
- Morata, A.; González, C.; Suárez-Lepe, J.A. Formation of vinylphenolic pyranoanthocyanins by selected yeasts fermenting red grape musts supplemented with hydroxycinnamic acids. Int. J. Food Microbiol. 2007, 116, 144–152. [Google Scholar] [CrossRef] [PubMed]
- García, M.; Esteve-Zarzoso, B.; Cabellos, J.M.; Arroyo, T. Advances in the Study of Candida stellate. Fermentation 2018, 4, 74. [Google Scholar] [CrossRef]
- Mora, J.; Mulet, A. Effects of some treatments of grape juice on the population and growth of yeast species during fermentation. Am. J. Enol. Vitic. 1991, 42, 133–136. [Google Scholar]
- Jackson, R.S. Wine Science-Principles, Practice, Perception, 2nd ed.; Academic Press: San Diego, CA, USA, 2000. [Google Scholar]
- Maurizio, C.; Ferraro, L. Enhanced glycerol content in wines made with immobilized Candida stellata cells. Appl. Environ. Microbiol. 1996, 62, 128–132. [Google Scholar]
- Ciani, M.; Maccarelli, F. Oenological properties of non-Saccharomyces yeasts associated with wine-making. World J. Microbiol. Biotechnol. 1998, 14, 199–203. [Google Scholar] [CrossRef]
- Magyar, I.; Tóth, T. Comparative evaluation of some oenological properties in wine strains of Candida stellata, Candida zemplinina, Saccharomyces uvarum and Saccharomyces cerevisiae. Food Microbiol. 2011, 28, 94–100. [Google Scholar] [CrossRef]
- Lafon-Lafourcade, S.; Lucmaret, V.; Joyeaux, A.; Ribereau-Gayon, P. Utilisation de levains mixtes dans l élaboration’des vins de pourriture noble en vue de réduire lácidité volatile. Comptes Rendues de L’Académie d’Agriculture 1981, 67, 616–622. [Google Scholar]
- Azzolini, M.; Tosi, E.; Lorenzini, M.; Finato, F.; Zapparoli, G. Contribution to the aroma of white wines by controlled Torulaspora delbrueckii cultures in association with Saccharomyces cerevisiae. World J. Microbiol. Biotechnol. 2015, 31, 277–293. [Google Scholar] [CrossRef] [PubMed]
- Azzolini, M.; Fedrizzi, B.; Tosi, E.; Finato, F.; Vagnoli, P.; Scrinzi, C.; Zapparoli, G. Effects of Torulaspora delbrueckii and Saccharomyces cerevisiae mixed cultures on fermentation and aroma of Amarone wine. Eur. Food Res. Technol. 2012, 235, 303–313. [Google Scholar] [CrossRef]
- Gordon, J.L.; Wolfe, K.H. Recent allopolyploid origin of Zygosaccharomyces rouxii strain ATCC 42981. Yeast 2008, 25, 449–456. [Google Scholar] [CrossRef] [PubMed]
- Steels, H.; James, S.A.; Roberts, I.N.; Stratford, M. Zygosaccharomyces lentus: A significant new osmophilic, preservative-resistant spoilage yeast, capable of growth at low temperature. J. Appl. Microbiol. 1999, 87, 520–527. [Google Scholar] [CrossRef] [PubMed]
- Romano, P.; Suzzi, G. Higher Alcohol and Acetoin Production by Zygosaccharomyces Wine Yeasts. J. Appl. Bacteriol. 1993, 75, 541–545. [Google Scholar] [CrossRef]
- Kurtzman, C.P.; Robnett, C.J.; Basehoar-Powers, E. Zygosaccharomyces kombuchaensis, a new ascosporogenous yeast from ‘Kombucha tea’. FEMS Yeast Res. 2001, 1, 133–138. [Google Scholar] [CrossRef] [PubMed]
- Kurtzman, C.P.; Robnett, C.J. Phylogenetic relationships among yeasts of the ‘Saccharomyces complex’ determined from multigene sequence analyses. FEMS Yeast Res. 2003, 3, 417–432. [Google Scholar] [CrossRef]
- Kurtzman, C.P. Phylogenetic circumscription of Saccharomyces Kluyveromyces and other members of the Saccharomycetaceae, and the proposal of the new genera Lachancea, Nakaseomyces, Naumovia, Vanderwaltozyma and Zygotorulaspora. FEMS Yeast Res. 2003, 4, 233–245. [Google Scholar] [CrossRef]
- Cabral, S.; Prista, C.; Loureiro-Dias, M.; Leandro, M. Occurrence of FFZ genes in yeasts and correlation with fructophilic behavior. Microbiology 2015, 161, 2008–2018. [Google Scholar] [CrossRef]
- Martorell, P.; Stratford, M.; Steels, H.; Fernández-Espinar, M.T.; Querol, A. Physiological characterization of spoilage strains of Zygosaccharomyces bailii, Zygosaccharomyces rouxii isolated from high sugar environments. Int. J. Food Microbiol. 2007, 114, 234–242. [Google Scholar] [CrossRef] [PubMed]
- Sá-Correia, I.; Guerreiro, J.F.; Loureiro-Dias, M.C.; Leão, C.; Côrte-Real, M. Zygosaccharomyces. In Encyclopedia of Food Microbiology, 2nd ed.; Batt, C.A., Tortorello, M.-L., Eds.; Academic Press: New York, NY, USA, 2014; Volume 3, pp. 849–855. [Google Scholar]
- Rankine, B.C. Decomposition of L-malic acid by wine yeasts. J. Sci. Food Agric. 1966, 17, 312–316. [Google Scholar] [CrossRef] [PubMed]
- Snow, P.G.; Gallander, J.F. Deacidification of white table wines through partial fermentation with Schizosaccharomyces pombe. Am. J. Enol. Vitic. 1979, 30, 45–48. [Google Scholar]
- Rodriquez, S.B.; Thornton, R.J. Factors influencing the utilization of L-malate by yeasts. FEMS Microbiol. Lett. 1990, 72, 17–22. [Google Scholar] [CrossRef]
- Seo, S.-H.; Rhee, C.-H.; Park, H.-D. Degradation of Malic Acid by Issatchenkia orientalis KMBL 5774, an Acidophilic Yeast Strain Isolated from Korean Grape Wine Pomace. J. Microbiol. 2007, 45, 521–527. [Google Scholar]
- Douglass, A.P.; Offei, B.; Braun-Galleani, S.; Coughlan, A.Y.; Martos, A.A.; Ortiz-Merino, R.A.; Byrne, K.P.; Wolfe, K.H. Population genomics shows no distinction between pathogenic Candida krusei and environmental Pichia kudriavzevii: One species, four names. PLoS Pathog. 2018, 14, e1007138. [Google Scholar] [CrossRef]
- Mills, D.A.; Johannsen, E.A.; Cocolin, L. Yeast diversity and persistence in botrytis-affected wine fermentations. Appl. Environ. Microbiol. 2002, 68, 4884–4893. [Google Scholar] [CrossRef]
- Englezos, V.; Rantsiou, K.; Torchio, F.; Rolle, L.; Gerbi, V.; Cocolin, L. Exploitation of the non-Saccharomyces yeast Starmerella bacillaris (synonym Candida zemplinina) in wine fermentation: Physiological and molecular characterizations. Int. J. Food Microbiol. 2015, 199, 33–40. [Google Scholar] [CrossRef]
- Magyar, I.; Nyitrai-Sárdy, D.; Leskó, A.; Pomázi, A.; Kállay, M. Anaerobic organic acid metabolism of Candida zemplinina in comparison with Saccharomyces wine yeasts. Int. J. Food Microbiol. 2014, 178, 1–6. [Google Scholar] [CrossRef]
- Romboli, Y.; Mangani, S.; Buscioni, G.; Granchi, L.; Vincenzini, M. Effect of Saccharomyces cerevisiae and Candida zemplinina on quercetin, vitisin A and hydroxytyrosol contents in Sangiovese wines. World J. Microbiol. Biotechnol. 2015, 31, 1137–1145. [Google Scholar] [CrossRef]
- Rantsiou, K.; Dolci, P.; Giacosa, S.; Torchio, F.; Tofalo, R.; Torriani, S.; Suzzi, G.; Rolle, L.; Cocolin, L. Candida zemplinina can reduce acetic acid production by Saccharomyces cerevisiae in sweet wine fermentations. Appl. Environ. Microbiol. 2012, 78, 1987–1994. [Google Scholar] [CrossRef] [PubMed]




| Fixed Acids | Volatile Acids | ||
|---|---|---|---|
| Major Acids | Minor Acids | Major Acids | Minor Acids |
| l-tartaric | Amino-acids | Acetic | Formic |
| (citrus-like taste) | (vinegar-like) | ||
| l-malic | Pyruvic | Propionic | |
| (metallic, green-apples taste) | |||
| l-lactic | α-Ketoglutaric | 2-Methylpropionic | |
| (sour and spicy) | |||
| Citric | Isocitric | Butyric | |
| (fresh and citrus-like) | |||
| Succinic | 2-Oxoglutaric | 2-Methylbutyric | |
| (sour, salty, and bitter) | |||
| Dimethyl glyceric | 3-Methylbutyric | ||
| Citramalic | Hexanoic | ||
| Gluconic acid (1) | Octanoic | ||
| Galacturonic | Decanoic | ||
| Glucuronic, Mucic, Coumaric, and Ascorbic | |||
| Yeast Species | Ethanol Formation (%, v/v) | Sugars Fermented | Volatile Compounds | Effect on Wine Acidity | Ref. |
|---|---|---|---|---|---|
Lachancea thermotolerans![]() | <9 | Glucose Fructose Maltose Galactose | 2-phenylethyl acetate Ethyl lactate | Acidity enrichment (lactic acid)/Acidity reduction (acetic acid) | [37,38,39,40] |
Schizosaccharomyces pombe![]() | 12–14 | Glucose Fructose Sucrose Maltose | Higher alcohols Esters | Maloalcoholic deacidification | [37,41] |
Candida stellate![]() | 10.6 + 9.81 gL−1 glycerol (in co-culture with S. cerevisiae) | Glucose Sucrose Raffinose (slow fermentation) | Esters Acetoin | Acidity enrichment (Succinic acid) | [42] |
Torulaspora delbrueckii![]() | 11 (table wine) 13-14 (i) (in co-culture with S. cerevisiae) | Glucose Galactose (ii) Maltose (ii) Sucrose (ii) a,a-Trehalose (ii) Melibiose (ii) | Long-chain alcohols, esters, aldehydes, and glycerol | Low production of acetic acid | [43,44,45] |
Z. florentinus/Z. Florentina![]() | >13 (iv) (in co-culture with S. cerevisiae) | Frutose (iii) Glucose Galactose Sucrose Maltose Raffinose Trehalose | higher alcohols and esters | Low production of acetic acid. Some species are able to consume acetic acid (v) | [46,47,48,49,50] |
Pichia kudriavzevii/Issatchenkia orientalis![]() | >7 (vi) (in microvinifications with chemically defined grape juice) | Glucose Fructose Sucrose, Maltose, Raffinose Xylose (vii) | Esters and Higher alcohols | Consume l-malic acid | [51,52] |
Starmerella bacillaris/Candida zemplinina![]() | 11.7–12.1 (viii) | Glucose Fructose (xix) | Higher level of some terpenes, lactones and thiols.(x) | Malic acid degradation; Reduction of acetic acid in sweet wines; Production of pyruvic acid. | [53,54,55,56,57] |
© 2019 by the author. Licensee MDPI, Basel, Switzerland. This article is an open access article distributed under the terms and conditions of the Creative Commons Attribution (CC BY) license (http://creativecommons.org/licenses/by/4.0/).
Share and Cite
Vilela, A. Use of Nonconventional Yeasts for Modulating Wine Acidity. Fermentation 2019, 5, 27. https://doi.org/10.3390/fermentation5010027
Vilela A. Use of Nonconventional Yeasts for Modulating Wine Acidity. Fermentation. 2019; 5(1):27. https://doi.org/10.3390/fermentation5010027
Chicago/Turabian StyleVilela, Alice. 2019. "Use of Nonconventional Yeasts for Modulating Wine Acidity" Fermentation 5, no. 1: 27. https://doi.org/10.3390/fermentation5010027
APA StyleVilela, A. (2019). Use of Nonconventional Yeasts for Modulating Wine Acidity. Fermentation, 5(1), 27. https://doi.org/10.3390/fermentation5010027